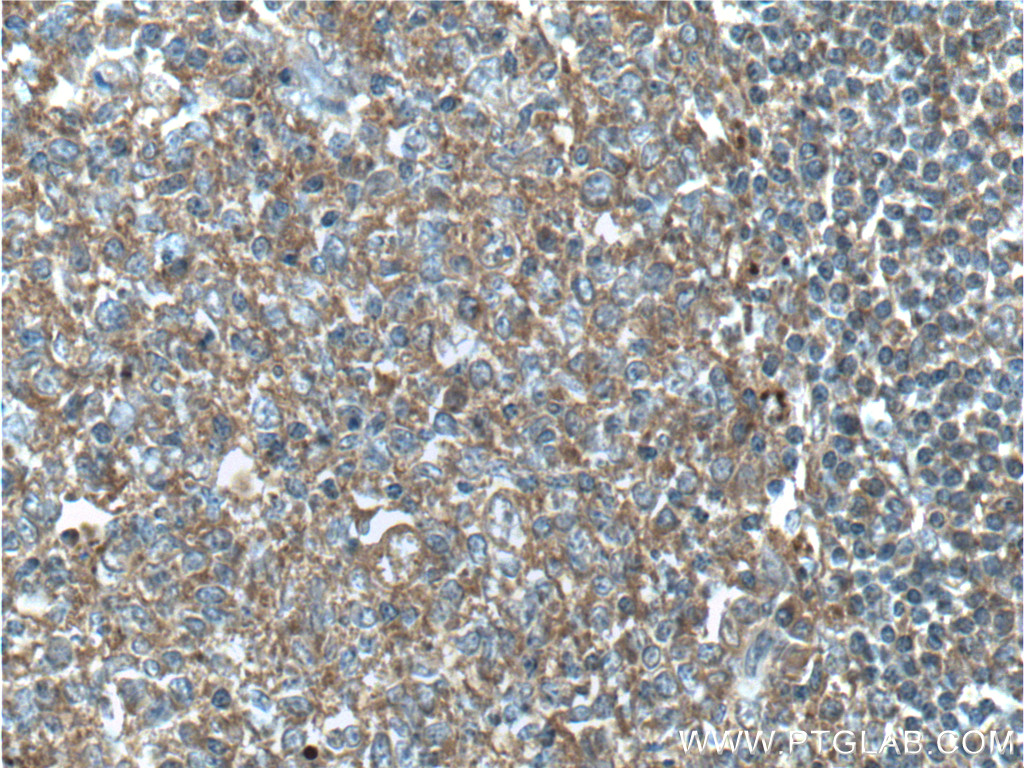

验证数据展示
经过测试的应用
| Positive WB detected in | A431 cells, HL-60 cells, mouse spleen tissue, rat spleen tissue |
| Positive IP detected in | HL-60 cells |
| Positive IHC detected in | human tonsillitis tissue, human renal cell carcinoma tissue Note: suggested antigen retrieval with TE buffer pH 9.0; (*) Alternatively, antigen retrieval may be performed with citrate buffer pH 6.0 |
推荐稀释比
| 应用 | 推荐稀释比 |
|---|---|
| Western Blot (WB) | WB : 1:500-1:1000 |
| Immunoprecipitation (IP) | IP : 0.5-4.0 ug for 1.0-3.0 mg of total protein lysate |
| Immunohistochemistry (IHC) | IHC : 1:50-1:500 |
| It is recommended that this reagent should be titrated in each testing system to obtain optimal results. | |
| Sample-dependent, Check data in validation data gallery. | |
发表文章中的应用
| KD/KO | See 1 publications below |
| WB | See 8 publications below |
产品信息
10735-1-AP targets RAC2 in WB, IHC, IP, ELISA applications and shows reactivity with human, mouse, rat samples.
| 经测试应用 | WB, IP, IHC, ELISA Application Description |
| 文献引用应用 | WB |
| 经测试反应性 | human, mouse, rat |
| 文献引用反应性 | human, mouse |
| 免疫原 |
CatNo: Ag1202 Product name: Recombinant human RAC2 protein Source: e coli.-derived, PGEX-4T Tag: GST Domain: 1-192 aa of BC001485 Sequence: MQAIKCVVVGDGAVGKTCLLISYTTNAFPGEYIPTVFDNYSANVMVDSKPVNLGLWDTAGQEDYDRLRPLSYPQTDVFLICFSLVSPASYENVRAKWFPEVRHHCPSTPIILVGTKLDLRDDKDTIEKLKEKKLAPITYPQGLALAKEIDSVKYLECSALTQRGLKTVFDEAIRAVLCPQPTRQQKRACSLL 种属同源性预测 |
| 宿主/亚型 | Rabbit / IgG |
| 抗体类别 | Polyclonal |
| 产品类型 | Antibody |
| 全称 | ras-related C3 botulinum toxin substrate 2 (rho family, small GTP binding protein Rac2) |
| 别名 | EN 7, Gx, HSPC022, p21 Rac2, RAC2, Small G protein |
| 计算分子量 | 21 kDa |
| 观测分子量 | 21 kDa |
| GenBank蛋白编号 | BC001485 |
| 基因名称 | RAC2 |
| Gene ID (NCBI) | 5880 |
| RRID | AB_2176127 |
| 偶联类型 | Unconjugated |
| 形式 | Liquid |
| 纯化方式 | Antigen affinity purification |
| UNIPROT ID | P15153 |
| 储存缓冲液 | PBS with 0.02% sodium azide and 50% glycerol, pH 7.3. |
| 储存条件 | Store at -20°C. Stable for one year after shipment. Aliquoting is unnecessary for -20oC storage. |
背景介绍
RAC2, also named as GX, belongs to the small GTPase superfamily and Rho family. RAC2 is a plasma membrane-associated small GTPase which cycles between an active GTP-bound and inactive GDP-bound state. In active state binds to a variety of effector proteins to regulate cellular responses, such as secretory processes, phagocytose of apoptotic cells and epithelial cell polarization. RAC2 augments the production of reactive oxygen species (ROS) by NADPH oxidase. Defects in RAC2 are the cause of neutrophil immunodeficiency syndrome.
实验方案
| Product Specific Protocols | |
|---|---|
| IHC protocol for RAC2 antibody 10735-1-AP | Download protocol |
| IP protocol for RAC2 antibody 10735-1-AP | Download protocol |
| WB protocol for RAC2 antibody 10735-1-AP | Download protocol |
| Standard Protocols | |
|---|---|
| Click here to view our Standard Protocols |
发表文章
| Species | Application | Title |
|---|---|---|
Nat Genet In vivo RNAi screening identifies regulators of actin dynamics as key determinants of lymphoma progression.
| ||
J Exp Clin Cancer Res Long noncoding RNA AFAP1-AS1 acts as a competing endogenous RNA of miR-423-5p to facilitate nasopharyngeal carcinoma metastasis through regulating the Rho/Rac pathway. | ||
Front Mol Neurosci Quantitative Proteomic Analysis of Mouse Sciatic Nerve Reveals Post-injury Upregulation of ADP-Dependent Glucokinase Promoting Macrophage Phagocytosis. | ||
Oncol Rep Upregulation and hypomethylation of lncRNA AFAP1‑AS1 predicts a poor prognosis and promotes the migration and invasion of cervical cancer. | ||
Biochem Biophys Res Commun Hsa_circ_001659 serves as a novel diagnostic and prognostic biomarker for colorectal cancer. | ||
Tumour Biol AFAP1-AS1, a long noncoding RNA upregulated in lung cancer and promotes invasion and metastasis. |